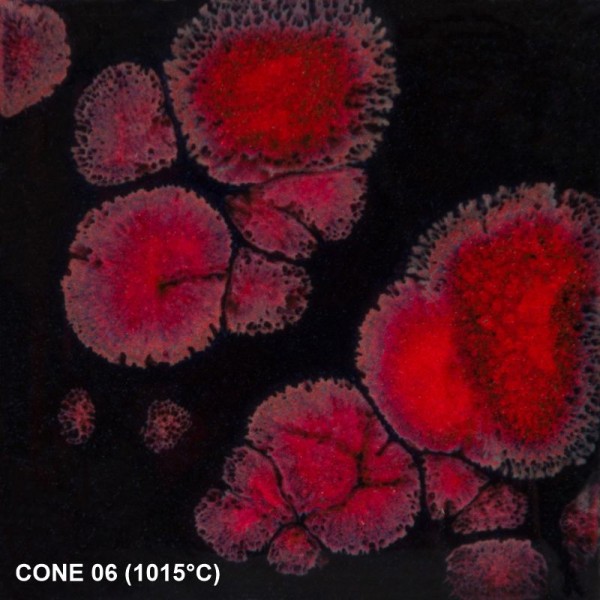
Mayco Jungle Gems CG779, Black Opal

Prices incl. VAT plus shipping costs
Ready to ship today,
Delivery time appr. 1-3 workdays
- Order number: CG-779
- EAN: 097539336847
Mayco CG-779 Black Opal – Effektglasur mit roten Kristallen (118 ml)
Entdecke die faszinierende Welt der Kristalleffekte mit der Mayco Jungle Gems CG-779 Black Opal. Diese undurchsichtige, tiefschwarze Basisglasur ist durchsetzt mit großen, leuchtend roten Kristallen, die beim Brennen einzigartige Muster und lebendige Akzente auf deiner Keramik entstehen lassen. Der starke Kontrast zwischen dem dunklen Hintergrund und den intensiven Kristalleffekten macht jedes Stück zu einem echten Blickfang.
Eigenschaften von Mayco Black Opal CG-779:
- Deckend schwarze Effektglasur mit kräftig roten Kristallen
- Beim Brennen entstehen dynamische Farbblüten und organische Muster
- Ideal für dekorative Keramikprojekte, Vasen, Schalen und Skulpturen
- Brennbereich: Cone 06 (ca. 1024°C)
- Kristallglasur aus der Jungle Gems-Serie von Mayco
- 118 ml Dose – perfekt für kleinere Projekte oder zum Ausprobieren
Wichtige Hinweise:
- Nicht lebensmittelecht – empfohlen für rein dekorative Zwecke
- Nicht für Sprühauftrag geeignet
- Jedes gebrannte Ergebnis ist ein Unikat – leichte Unterschiede sind typisch für Kristallglasuren
- Für Hobbykeramiker, Kunsthandwerker und kreative Keramikstudios
Jetzt Mayco CG-779 Black Opal (118 ml) bestellen und mit ausdrucksstarken Kristalleffekten kreative Keramikkunstwerke gestalten!
Anwendung: Vor jeder Anwendung gut schütteln und umrühren, um die Kristalle in der Glasur zu verteilen. Verwenden Sie einen Fächerpinsel und tragen Sie 2-3 gleichmäßige Schichten auf geschrühte Keramik (Cone 04, 1060 °C) auf. Zwischen den Schichten trocknen lassen. Während des Auftragens der dritten Schicht müssen die Kristalle möglicherweise neu verteilt werden, um eine gleichmäßige Abdeckung zu gewährleisten. Vermeiden Sie es, Kristalle in die Nähe des Bodens des Werkstücks zu platzieren, da die Kristalle aufgrund ihrer Fließeigenschaften verlaufen können. Gut trocknen lassen. Brennen Sie die Glasur bei Cone 06/05 (999 °C – 1046 °C). Besuchen Sie MaycoColors.com für vollständige Sicherheitsdaten (SDS) und weitere Produktinformationen.
Ungiftig und nicht gefährlich, wenn gemäß den Herstellerangaben verwendet. Nicht sprühauftragbar. Nicht für Geschirr empfohlen, da die Oberfläche evtl. Krakteliert und daher nicht für den Kontakt mit Lebensmitteln geeignet ist; nur für dekorative Zwecke.

| Produktgruppen Glasuren: | Irdenware 1020° - 1100°C |
| Deckkraft Glasur: | deckend |
| Farbton Glasur: | Schwarz |
| Gebindegröße Glasur: | 118 ml / 4 fl oz |